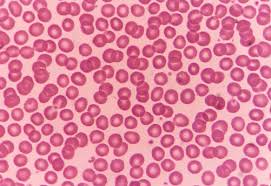
백혈구 정상수치

백혈구 정상수치 알아보기
백혈구는 우리 몸의 면역 시스템에서 매우 중요한 역할을 합니다. 외부에서 침입하는 세균, 바이러스 등을 방어하고, 암세포를 제거하며, 염증 반응을 조절합니다. 따라서 백혈구 수치는 우리의 건강 상태를 직간접적으로 알려주는 중요한 지표 중 하나입니다. 이번 글에서는 백혈구 정상수치와 관련된 다양한 정보들을 상세히 알아보겠습니다.

백혈구의 역할과 중요성
백혈구의 기능
백혈구는 우리 몸의 면역 시스템에서 핵심적인 역할을 합니다. 백혈구의 주요 기능은 다음과 같습니다:
- 세균과 바이러스 방어: 백혈구는 외부에서 침입하는 세균과 바이러스를 탐지하고 제거합니다.
- 암세포 제거: 비정상적인 세포나 암세포를 발견하여 제거합니다.
- 염증 반응 조절: 상처가 생기거나 감염이 발생했을 때 염증 반응을 조절하여 치유 과정을 돕습니다.
백혈구의 종류
백혈구는 여러 종류로 나뉘며, 각각의 종류는 특정한 역할을 담당합니다. 주요 백혈구의 종류는 다음과 같습니다:
- 호중구: 세균 감염에 대항하는 주요 세포로, 전체 백혈구의 약 60-70%를 차지합니다.
- 림프구: 바이러스 감염에 대항하며, B 림프구와 T 림프구로 나뉩니다.
- 단핵구: 대식세포로 변해 세균과 세포 찌꺼기를 제거합니다.
- 호산구: 기생충 감염과 알레르기 반응에 관여합니다.
- 호염구: 히스타민과 같은 화학물질을 방출하여 알레르기 반응을 유발합니다.



백혈구 정상수치란?
백혈구 정상수치 범위
백혈구의 정상수치는 성인의 경우 혈액 1마이크로리터당 약 4,000에서 10,000개 정도입니다. 이 범위를 벗어나면 다양한 건강 문제를 의심해 볼 수 있습니다.
- 성인: 4,000-10,000개/μL
- 신생아: 9,000-30,000개/μL (생후 첫 주)
- 소아: 5,000-15,000개/μL
백혈구 수치가 높은 경우
백혈구 수치가 정상 범위를 초과하면 감염, 염증, 스트레스, 백혈병 등의 질환을 의심할 수 있습니다. 높은 백혈구 수치의 원인과 증상에 대해 자세히 살펴보겠습니다.
원인
- 감염: 세균, 바이러스, 기생충 등에 의한 감염이 백혈구 수치를 증가시킬 수 있습니다.
- 염증: 관절염, 염증성 장질환 등 염증성 질환이 백혈구 수치를 높일 수 있습니다.
- 조직 손상: 화상, 외상 등으로 인해 백혈구 수치가 증가할 수 있습니다.
- 스트레스: 감정적, 육체적 스트레스가 백혈구 수치에 영향을 줄 수 있습니다.
- 약물 반응: 스테로이드, 베타 길항제, 호르몬제 등의 약물이 백혈구 수치를 높일 수 있습니다.
증상
백혈구 수치가 높아지면 다음과 같은 증상이 나타날 수 있습니다:
- 발열
- 피로
- 어지러움
- 체중 감소
- 호흡 곤란
증상이 없을 수도 있지만, 백혈구 수치가 지속적으로 높다면 원인을 찾고 치료하는 것이 중요합니다.



백혈구 수치가 낮은 경우
백혈구 수치가 정상 범위보다 낮으면 면역력이 약해져 감염에 더 취약해질 수 있습니다. 낮은 백혈구 수치의 원인과 증상에 대해 자세히 알아보겠습니다.
원인
- 면역력 저하: 영양 부족, 만성 피로, 스트레스 등이 원인이 될 수 있습니다.
- 약물 부작용: 항암제, 항우울제, 안정제 등의 약물이 백혈구 수치를 낮출 수 있습니다.
- 질병: 자가면역질환, 골수 질환, 재생불량성 빈혈 등이 백혈구 수치를 낮출 수 있습니다.
증상
백혈구 수치가 낮아지면 다음과 같은 증상이 나타날 수 있습니다:
- 감염 빈도 증가
- 피로
- 설사
- 고열
- 인후염
- 소변 시 통증
이러한 증상이 지속된다면, 백혈구 수치 검사를 통해 원인을 찾아야 합니다.



백혈구 수치를 높이는 방법
백혈구 수치를 높이기 위해서는 다양한 방법이 있습니다. 여기에는 생활 습관 개선과 영양 섭취가 포함됩니다.
균형 잡힌 식사
비타민 B, 엽산, 아연 등이 풍부한 음식을 섭취하는 것이 중요합니다. 다음과 같은 음식이 도움이 됩니다:
- 녹색 잎채소 (시금치, 케일)
- 콩류 (렌틸콩, 병아리콩)
- 견과류 (호두, 아몬드)
- 시리얼 (통곡물 시리얼)
규칙적인 운동
규칙적인 운동은 면역력을 높이는 데 도움이 됩니다. 적당한 운동을 통해 체력을 기르고, 면역 시스템을 강화할 수 있습니다.
스트레스 관리
스트레스는 백혈구 수치에 직접적인 영향을 줄 수 있습니다. 스트레스를 관리하기 위해 명상, 요가 등을 실천하는 것이 좋습니다.
충분한 수면
면역 시스템이 제대로 작동하려면 충분한 수면이 필수적입니다. 하루에 최소 7-8시간의 수면을 취하는 것이 좋습니다.



백혈구 수치를 낮추는 방법
백혈구 수치가 너무 높아도 문제가 될 수 있습니다. 이를 낮추기 위해서는 다음과 같은 방법을 고려할 수 있습니다.
스트레스 관리
스트레스는 백혈구 수치에 영향을 줄 수 있습니다. 명상, 요가, 심호흡 등의 방법으로 스트레스를 줄이는 것이 좋습니다.
적절한 약물 사용
과도한 약물 사용을 피하고, 의료진과 상의하여 적절한 약물을 사용하는 것이 중요합니다.
규칙적인 검진
정기적인 검진을 통해 백혈구 수치를 모니터링하고, 이상이 발견되면 즉시 조치하는 것이 필요합니다.






결론
백혈구 수치는 우리의 건강 상태를 보여주는 중요한 지표입니다. 너무 높거나 낮으면 다양한 건강 문제가 발생할 수 있기 때문에, 정기적인 검사를 통해 백혈구 수치를 체크하고, 필요할 경우 적절한 조치를 취하는 것이 중요합니다. 건강한 생활 습관을 유지하는 것이 백혈구 수치를 정상으로 유지하는 데 큰 도움이 됩니다.

FAQ
1. 백혈구 수치가 높으면 무슨 문제가 생기나요?
백혈구 수치가 높으면 감염, 염증, 스트레스, 약물 반응 등 다양한 원인이 있을 수 있습니다. 원인에 따라 적절한 치료가 필요합니다.
2. 백혈구 수치가 낮으면 어떻게 해야 하나요?
백혈구 수치가 낮으면 면역력을 높이기 위해 영양 보충, 규칙적인 운동, 스트레스 관리 등이 필요합니다. 심각한 경우 의료진과 상담하여 적절한 치료를 받아야 합니다.
3. 백혈구 수치가 정상 범위에서 벗어나면 어떤 증상이 나타날 수 있나요?
백혈구 수치가 높거나 낮으면 피로, 감염 빈도 증가, 체중 감소, 식욕 저하 등의 증상이 나타날 수 있습니다.
4. 백혈구 수치는 어떻게 측정하나요?
백혈구 수치는 일반적인 혈액검사를 통해 측정할 수 있습니다.
5. 백혈구 수치를 높이기 위한 자연적인 방법은 무엇인가요?
비타민이 풍부한 음식 섭취, 규칙적인 운동, 충분한 수면, 스트레스 관리 등이 도움이 됩니다.
6. 백혈구 수치가 낮을 때 어떤 음식을 먹으면 좋을까요?
비타민 B, 엽산, 아연 등이 풍부한 음식이 도움이 됩니다. 예를 들어, 녹색 잎채소, 콩류, 견과류, 시리얼 등이 있습니다.
7. 백혈구 수치가 높은 것이 항상 나쁜 것인가요?
백혈구 수치가 높다고 항상 나쁜 것은 아닙니다. 일시적인 스트레스, 감염 등에 의한 상승일 수 있으나, 지속적으로 높다면 원인을 찾아 치료하는 것이 필요합니다.
'생활정보' 카테고리의 다른 글
| 산업안전기사 취업 전망: 당신의 커리어를 바꿀 기회! (0) | 2024.07.07 |
|---|---|
| 국민청원 홈페이지 바로가기 (0) | 2024.07.06 |
| 운전면허적성검사 갱신 온라인 신청방법 (1) | 2024.07.06 |
| 김해공항 리무진 버스 시간표 (0) | 2024.07.06 |
| 당화혈색소 정상치 알아보자 (0) | 2024.07.06 |
댓글